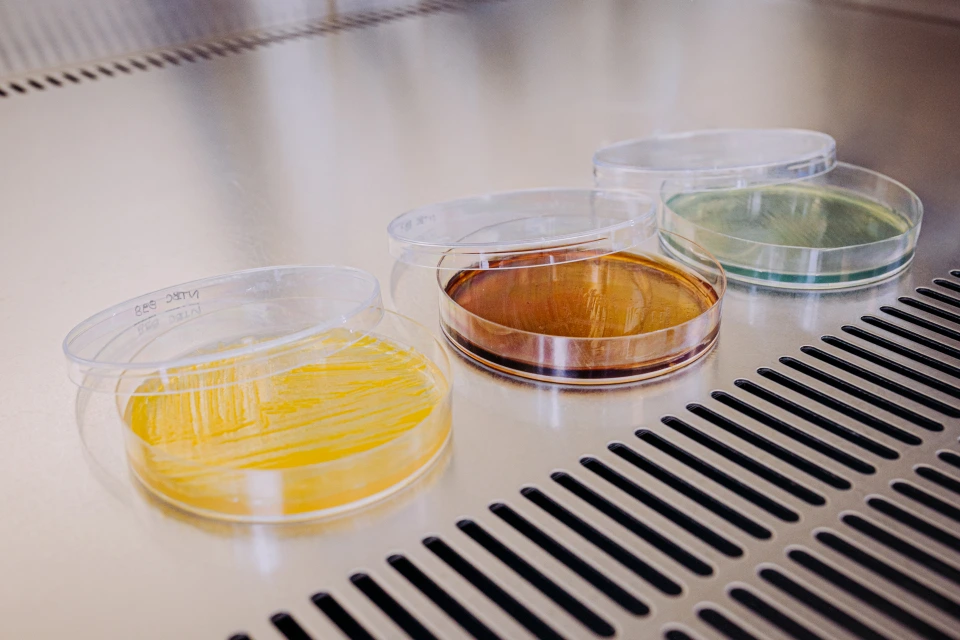

FIGHTING
Drug Resistant Infections
We are a privately-held clinical-stage biopharmaceutical company developing novel antibacterials targeting drug-resistant pathogens that are deemed a critical priority by the WHO.
Antimicrobial Resistance
A Growing Global Emergency
5–10%
Of patients acquire a healthcare-associated infection in acute care hospitals
1.14M deaths (2021)
Deaths attributable to bacterial AMR
Projected global mortality from antimicrobial resistance
US$412B
Potential annual additional healthcare expenditure globally due to AMR

Who we are
Expert and Complementary Team
Antabio is a clinical stage biopharmaceutical company developing novel antibacterial treatments targeting drug‑resistant infections identified by WHO and CDC as critical priorities, with a particular focus on life-threatening hospital infections.
The company’s lead program, Meropenem-Pilabactam (MEM-PIL, formerly MEM‑ANT3310), is a next‑generation β‑lactam/β‑lactamase inhibitor (BL/BLI) combination designed to treat multi drug-resistant infections in hospital wards and ICUs. Antabio is supported by leading strategic and institutional investors such as the AMR Action Fund, EIC Fund, BNP Paribas Développement, Turenne/Relyens Santé, and IRDI Capital Investment.

Our mission
Fighting Resistance
Our mission is to develop innovative, highly differentiated antibacterial therapies for patients suffering from severe, hard-to-treat infections caused by multidrug-resistant Gram-negative bacteria.
We focus on delivering effective solutions targeting WHO and CDC priority pathogens, with a particular emphasis on life-threatening hospital–acquired infections. Through scientific excellence, strategic development, and a diversified pipeline, we aim to restore the efficacy of antibiotics and play a leading role in the global fight against antimicrobial resistance.
Events & Conferences
Where to meet Antabio
Our Pipeline
MEM-PIL
IV serine B-lactamase inhibitor combined with meropenemINDICATION
HABP/VABP, BSI
DEVELOPMENT STAGE
DISCOVERY
PRECLINICAL
PHASE 1
PHASE 2
PHASE 3
PEi
Inhaled Pseudomonas aeruginosaelastase inhibitorINDICATION
Chronic Respiratory Diseases
DEVELOPMENT STAGE
DISCOVERY
PRECLINICAL
PHASE 1
PHASE 2
PHASE 3
Novel Target / Novel Chemical Series
Three programs on novel targets / novel chemical seriesINDICATION
Oral/IV,
Nosocomial Infections
In collaboration with

DEVELOPMENT STAGE
DISCOVERY
PRECLINICAL
PHASE 1
PHASE 2
PHASE 3
Novel Target 2
SMALL MOLECULEINDICATION
Oral/IV,
Nosocomial Infections
DEVELOPMENT STAGE
DISCOVERY
PRECLINICAL
PHASE 1
PHASE 2
PHASE 3
